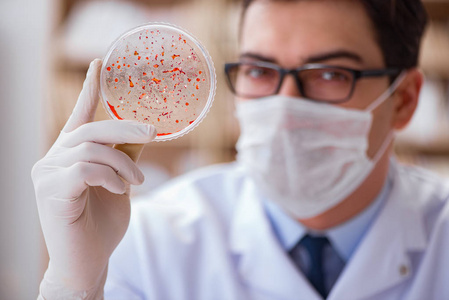
细菌实验图片

细菌试验

微生物实验室中科学家实验室技术员接种环培养板细菌接种研究
图片尺寸700x467
一个人,方图,室内,安全,检查,研究,科学,细菌,圆形,实验室,防护,拿着
图片尺寸819x819
2012级初二年级开展培养细菌真菌实验结论交流活动
图片尺寸830x300
研究在实验室中的细菌的医生
图片尺寸700x467
细菌总数#改良平皿法#实验室生活# - 抖音
图片尺寸887x1920
关于手部细菌情况的实验
图片尺寸1230x556![主题:【分享】探访超级细菌实验室[高清组图]](https://i.ecywang.com/upload/1/img0.baidu.com/it/u=1297662650,1226937060&fm=253&fmt=auto&app=138&f=JPEG?w=753&h=500)
主题:【分享】探访超级细菌实验室[高清组图]
图片尺寸900x598
细菌学图片
图片尺寸452x350
细菌分析图片
图片尺寸450x300
兴济镇港西学校二年级爱护卫生细菌观察实验
图片尺寸4032x3024
探访监测超级细菌的微生物实验室
图片尺寸400x299
生物,欧洲,欧洲人,仅一个人,许多,握,阴影,研究,分析,光线,化学,细菌
图片尺寸621x819
探访超级细菌实验室(高清组图)
图片尺寸900x598
细菌科学实验拍摄高清图片
图片尺寸820x656
微生物实验室一名女性研究人员进行细菌培养板检查
图片尺寸1200x800
美军有多狠!为了实验细菌武器,在机场与车站秘密投放细菌
图片尺寸640x601
人鼻内细菌(金黄色葡萄球菌)的研究,血液琼脂培养板的实验室微生物学
图片尺寸1200x800
琼脂片中的细菌,实验室感染测试,革兰氏阴性菌的生长,革兰氏阴性菌
图片尺寸1200x800
细菌实验图片
图片尺寸449x300
细菌实验图片
图片尺寸449x300






![主题:【分享】探访超级细菌实验室[高清组图]](https://i.ecywang.com/upload/1/img0.baidu.com/it/u=1297662650,1226937060&fm=253&fmt=auto&app=138&f=JPEG?w=753&h=500)
















![主题:【分享】探访超级细菌实验室[高清组图]](https://img.ycwb.com/news/attachement/jpg/site2/20101030/90fba60187190e35b72d07.jpg)